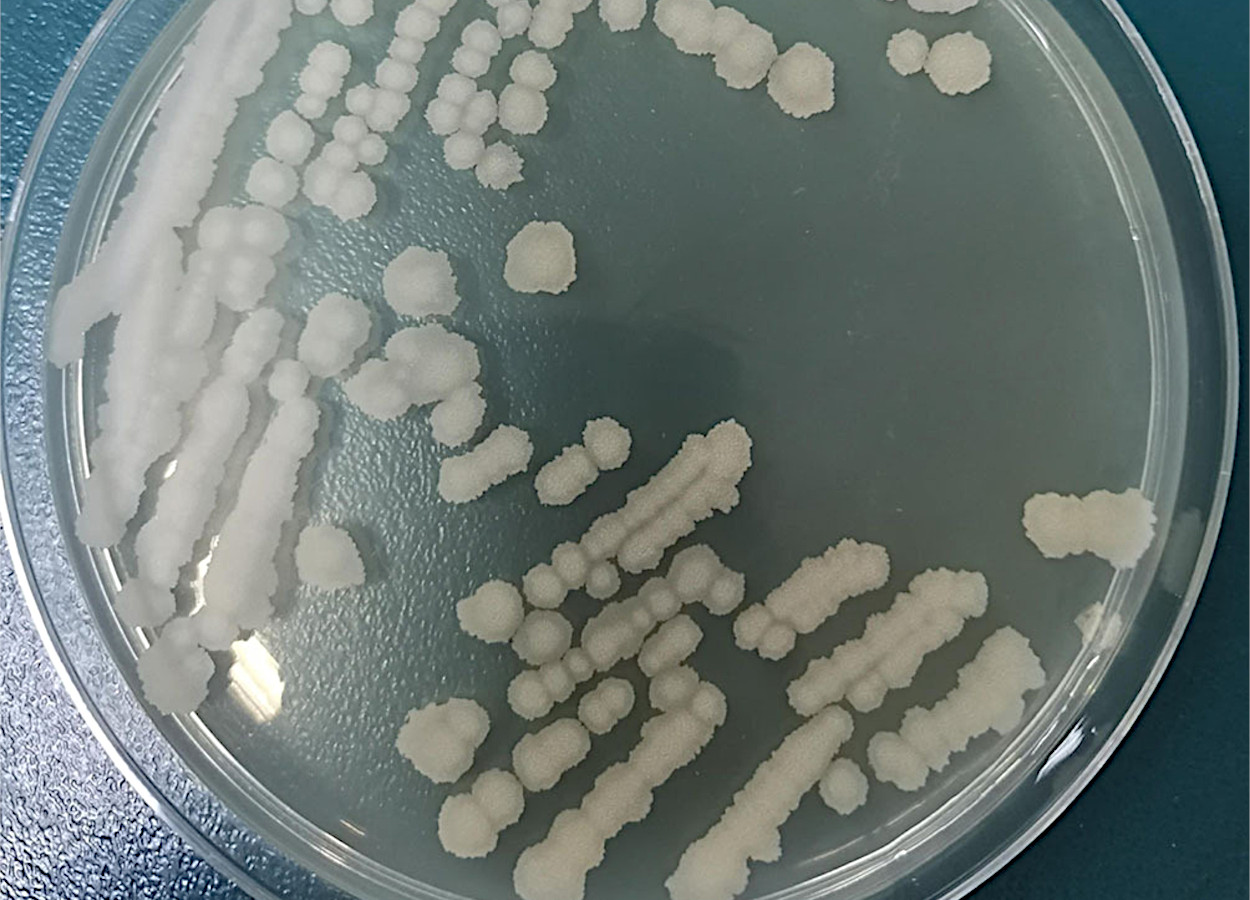

Bacillus siamensis é uma das espécies mais promissoras no panorama da microbiologia aplicada à agricultura.
Descrita pela primeira vez em 2010 a partir de uma amostra isolada de caranguejo salgado (poo-khem) na Tailândia, essa bactéria Gram-positiva, aeróbia ou anaeróbia facultativa, integra o complexo de espécies Bacillus subtilis, especificamente o grupo operacional B. amyloliquefaciens.
Do ponto de vista taxonômico, B. siamensis exemplifica a complexidade filogenética do gênero Bacillus, que tem sido reestruturado por avanços em genômica comparativa.
Pertencente ao domínio Bacteria, filo Bacillota, classe Bacilli, ordem Bacillales, família Bacillaceae e gênero Bacillus, sua classificação segue o Código Internacional de Nomenclatura de Procariontes (ICNP) e é registrada no NCBI Taxonomy com ID 659243.
O nome "siamensis" homenageia a antiga designação da Tailândia (Siam), refletindo sua origem geográfica. Emendada por Dunlap em 2015, a espécie apresenta sinônimos como o heterotípico "Bacillus vanillea" (não validado), e distingue-se de congêneres próximas, como B. amyloliquefaciens e B. velezensis, por baixa hibridização de DNA-DNA (<70%), apesar de altas similaridades em sequências de 16S rRNA (99,2–99,5%).
Análises baseadas em genes como rpoB e genomas centrais reforçam sua inserção no grupo amyloliquefaciens, um clado adaptado a nichos rizosféricos, onde a divergência genética sustenta adaptações fenotípicas únicas, como a tolerância salina.
A biologia de Bacillus siamensis revela uma bactéria resiliente e multifuncional. Suas características morfológicas, fisiológicas e genéticas a equipam para colonizar ambientes hostis.
Morfologicamente, exibe células bastonete (0,5–1,0 μm de largura por 2,0–4,0 μm de comprimento), móveis por flagelos peritricos e formadoras de endósporos ovais centrais ou subterminais, conferindo resistência a estresses térmicos e químicos. Suas colônias em ágar nutriente são circulares, lisas e de cor creme, crescendo otimamente a 30–37°C, pH 7,0 e 0–2% NaCl, com tolerância ampla (4–55°C, pH 4,5–9,0, até 14% NaCl).
Bioquimicamente, é catalase-positiva, hidrolisa amido e caseína, reduz nitrato e produz acetoin, mas não indóis ou fermenta lactose; quimiotaxonomicamente, destaca-se pela menaquinona-7 (MK-7) e ácidos graxos como anteiso-C15:0 (40–50%).
Geneticamente, seu cromossomo circular de 3,9–4,1 Mb (G+C 41,4 mol%) codifica biossíntese de lipopeptídeos antifúngicos (bacilomicina, fengicinas, surfactinas), solubilização de fosfatos e fixação de nitrogênio, além de clusters para resistência abiótica. Cepas como B28 ilustram essa versatilidade, com genes que modulam respostas vegetais a patógenos, posicionando B. siamensis como um microorganismo promotor de crescimento (PGPR) eficiente.
Ecologicamente, Bacillus siamensis é ubíqua. Ocupa nichos que vão de solos agrícolas a ecossistemas marinhos, onde atua como modulador de comunidades microbianas.
Predominante em rizosferas de culturas como arroz, soja, tomate e banana, coloniza endofiticamente tecidos vegetais, promovendo simbioses que aumentam a absorção de nutrientes e reduzem espécies reativas de oxigênio (ROS). Sua halotolerância a torna ideal para solos salinos e manguezais, enquanto isolamentos de ninhos de cupins e alimentos fermentados (ex.: soja orgânica) sugerem papéis em ciclos biogeoquímicos, como a fermentação e a disseminação via vetores insetos.
Em interações com plantas, compete por nutrientes, elicita defesas sistêmicas e produz sideróforos e auxinas, reprogramando genes para maior resiliência. Essa dinâmica ecológica não é isolada; ela integra B. siamensis em microbiomas rizosféricos, onde equilibra populações patogênicas e abióticas, fomentando biodiversidade microbiana e sustentabilidade ambiental.
No âmbito etiológico, Bacillus siamensis subverte expectativas tradicionais de patogenicidade associadas ao gênero Bacillus, atuando predominantemente como antagonista benéfico.
Ausente de fatores de virulência como toxinas ou adesinas, não causa infecções em plantas, humanos ou animais; ao contrário, seu papel é protetor, inibindo fitopatogênos como Fusarium oxysporum, Magnaporthe oryzae e Colletotrichum spp.
Cepas como GP-P8 e QN2MO-1 reduzem incidências de doenças em até 70%, via mecanismos como competição espacial, produção de metabólitos antimicrobianos e indução de imunidade vegetal.
Em contextos agrícolas, isso se traduz em diminuição de damping-off (60% de redução) e antracnose, promovendo rendimentos sem resíduos químicos. Sua etiologia indireta reforça o conceito de agricultura integrada, onde B. siamensis mitiga riscos epidemiológicos em rotação de culturas.